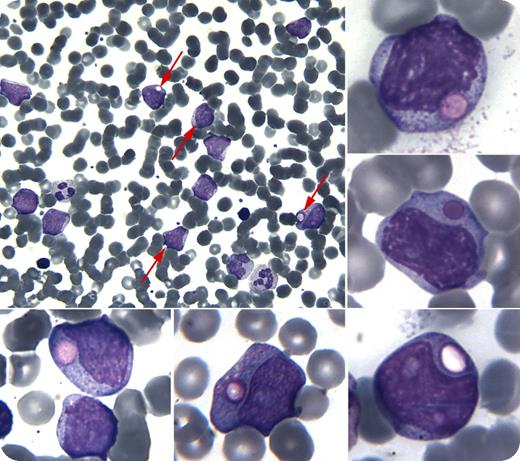
A 27-year-old woman presented with multiple red to violaceous dermal nodules on the scalp, abdomen, and external genitalia, and masses in the left breast. A skin biopsy specimen obtained from her left abdomen was suggestive of myeloid sarcoma. A complete blood count showed 40% blasts. Many of the blasts had giant azurophilic granules, some vacuolated, so-called pseudo Chediak-Higashi anomaly (see arrows within the main panel, and the smaller subpanels). Flow cytometry immunophenotypic analysis on blood showed 46% blasts positive for CD4, CD11c, CD33, CD34, and CD64 and negative for myeloperoxidase, CD13, CD117, and lymphoid markers, supporting a monoblastic/monocytic lineage and the diagnosis of acute monoblastic leukemia (FAB M5). Bone marrow showed acute monoblastic leukemia, and many blasts had pseudo Chediak-Higashi anomaly; conventional cytogenetics were normal, and the NPM1 mutation was present. The patient received chemotherapy and underwent complete remission. / The pseudo Chediak-Higashi anomaly has been reported in acute myeloid leukemia, chronic myeloid leukemia, and myelodysplastic syndromes. Two mechanisms have been suggested for pseudo Chediak-Higashi anomaly: fusion of Golgi-derived or primary granules, or fusion of granules with cell organelles forming a giant autophagic granule. The pathophysiology of pseudo Chediak-Higashi anomaly is unknown.

A 27-year-old woman presented with multiple red to violaceous dermal nodules on the scalp, abdomen, and external genitalia, and masses in the left breast. A skin biopsy specimen obtained from her left abdomen was suggestive of myeloid sarcoma. A complete blood count showed 40% blasts. Many of the blasts had giant azurophilic granules, some vacuolated, so-called pseudo Chediak-Higashi anomaly (see arrows within the main panel, and the smaller subpanels). Flow cytometry immunophenotypic analysis on blood showed 46% blasts positive for CD4, CD11c, CD33, CD34, and CD64 and negative for myeloperoxidase, CD13, CD117, and lymphoid markers, supporting a monoblastic/monocytic lineage and the diagnosis of acute monoblastic leukemia (FAB M5). Bone marrow showed acute monoblastic leukemia, and many blasts had pseudo Chediak-Higashi anomaly; conventional cytogenetics were normal, and the NPM1 mutation was present. The patient received chemotherapy and underwent complete remission.
The pseudo Chediak-Higashi anomaly has been reported in acute myeloid leukemia, chronic myeloid leukemia, and myelodysplastic syndromes. Two mechanisms have been suggested for pseudo Chediak-Higashi anomaly: fusion of Golgi-derived or primary granules, or fusion of granules with cell organelles forming a giant autophagic granule. The pathophysiology of pseudo Chediak-Higashi anomaly is unknown.
A 27-year-old woman presented with multiple red to violaceous dermal nodules on the scalp, abdomen, and external genitalia, and masses in the left breast. A skin biopsy specimen obtained from her left abdomen was suggestive of myeloid sarcoma. A complete blood count showed 40% blasts. Many of the blasts had giant azurophilic granules, some vacuolated, so-called pseudo Chediak-Higashi anomaly (see arrows within the main panel, and the smaller subpanels). Flow cytometry immunophenotypic analysis on blood showed 46% blasts positive for CD4, CD11c, CD33, CD34, and CD64 and negative for myeloperoxidase, CD13, CD117, and lymphoid markers, supporting a monoblastic/monocytic lineage and the diagnosis of acute monoblastic leukemia (FAB M5). Bone marrow showed acute monoblastic leukemia, and many blasts had pseudo Chediak-Higashi anomaly; conventional cytogenetics were normal, and the NPM1 mutation was present. The patient received chemotherapy and underwent complete remission.
The pseudo Chediak-Higashi anomaly has been reported in acute myeloid leukemia, chronic myeloid leukemia, and myelodysplastic syndromes. Two mechanisms have been suggested for pseudo Chediak-Higashi anomaly: fusion of Golgi-derived or primary granules, or fusion of granules with cell organelles forming a giant autophagic granule. The pathophysiology of pseudo Chediak-Higashi anomaly is unknown.
For additional images, visit the ASH IMAGE BANK, a reference and teaching tool that is continually updated with new atlas and case study images. For more information visit http://imagebank.hematology.org.